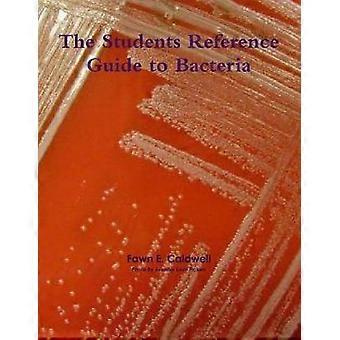

Reference
Shop the best prices on 39,591 great value reference. Shopping for reference is easy with Fruugo, with SALE discounts, offers and savings on Taylor & Francis Ltd, Bloomsbury Publishin, Thames & Hudson Ltd and more. Buy reference online safely with Fruugo, with secure payment and fast shipping to Canada.
Filters
2,625 - 2,656 of 3,200